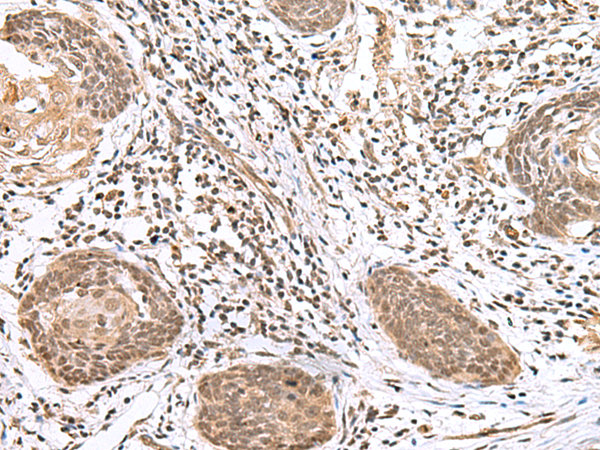

|
Background: |
This gene encodes a protein which belongs to the C2H2-type zinc finger protein subclass of the Gli family. Members of this subclass are characterized as transcription factors which bind DNA through zinc finger motifs. These motifs contain conserved H-C links. Gli family zinc finger proteins are mediators of Sonic hedgehog (Shh) signaling and they are implicated as potent oncogenes in the embryonal carcinoma cell. The protein encoded by this gene localizes to the cytoplasm and activates patched Drosophila homolog (PTCH) gene expression. It is also thought to play a role during embryogenesis. The encoded protein is associated with several phenotypes- Greig cephalopolysyndactyly syndrome, Pallister-Hall syndrome, preaxial polydactyly type IV, postaxial polydactyly types A1 and B. |
|
Applications: |
ELISA, IHC |
|
Name of antibody: |
GLI2 |
|
Immunogen: |
Synthetic peptide of human GLI2 |
|
Full name: |
GLI family zinc finger 2 |
|
Synonyms: |
CJS; HPE9; PHS2; THP1; THP2 |
|
SwissProt: |
P10070 |
|
ELISA Recommended dilution: |
5000-10000 |
|
IHC positive control: |
Human esophagus cancer and Human ovarian cancer |
|
IHC Recommend dilution: |
25-100 |

購(gòu)物車(chē)
購(gòu)物車(chē) 幫助
幫助
 021-54845833/15800441009
021-54845833/15800441009
